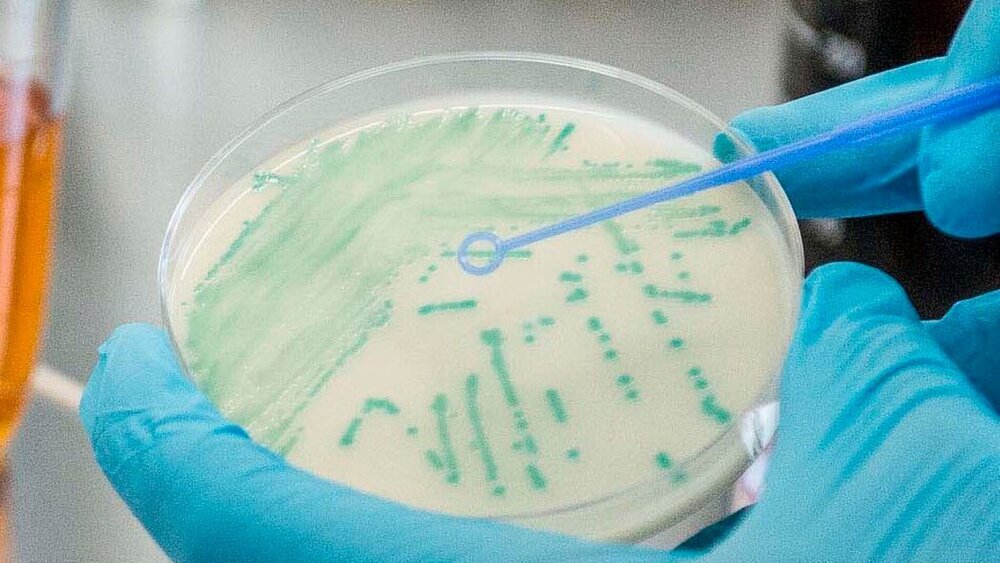

Bakterien tauschen Resistenzgene untereinander aus
Bakterien, die gegen Breitband-Antibiotika aus der Gruppe der Carbapeneme resistent sind, stellen die Gesundheitssysteme weltweit zunehmend vor große Probleme. Sie können schwere Infektionen und Ausbruchsituationen verursachen, für die es nur sehr begrenzte oder gar keine Therapieoptionen gibt. Dabei kommt den Bakterien zugute, dass sie genetisches Material – und damit auch Resistenzgene – untereinander austauschen können.
Hochrisiko-Plasmid ist auch noch über Jahre hinweg aktiv
Eine Form dieses horizontalen Gentransfers erfolgt bei Bakterien über sogenannte Plasmide – mobile, autonom replizierende DNA-Moleküle, die in Bakterien vorkommen, aber nicht zu deren Chromosom gehören. Wissenschaftler des Instituts für Medizinische Mikrobiologie der Justus-Liebig-Universität Gießen (JLU) und des Deutschen Zentrums für Infektionsforschung (DZIF) konnten zusammen mit Kollegen aus dem öffentlichen Gesundheitswesen nun ein besonders stabiles Plasmid nachweisen, das in Deutschland für einen Großteil der bakteriellen Resistenzen gegen Antibiotika verschiedener Gruppen einschließlich der Carbapeneme verantwortlich ist. Dieses Hochrisiko-Plasmid kann nicht nur auf unterschiedliche Bakterien-Spezies übertragen werden, es ist auch noch über Jahre hinweg aktiv.
Eine der weltweit wichtigsten und häufigsten Ursachen für die bakterielle Carbapenem-Resistenz ist das Enzym KPC-2-Carbapenemase, das Carbapeneme unschädlich macht. Die Wissenschaftler wiesen nach, dass regional rund 85 Prozent aller Erreger, die eine KPC-2-Carbapenemase produzieren können, ein nahezu identisches Plasmid tragen, das der Gruppe der IncN-Plasmide angehört. Dieses erstmals beschriebene Plasmid kodiert verschiedene Antibiotikaresistenzgene und zeigt ein sehr breites bakterielles Wirtsspektrum. Es kann innerhalb eines Patienten schnell von einem Bakterium auf das andere übertragen werden, auch auf andere Bakterienarten. Im Falle eines Ausbruchs – zum Beispiel bei den gefürchteten Krankenhaus-Infektionen – findet man also völlig unterschiedliche bakterielle Erreger, die alle das identische Plasmid tragen.
Es wurde nachgewiesen in elf verschiedenen bakteriellen Spezies
Im Fokus der in der Fachzeitschrift Micobiology Spectrum veröffentlichten Studie standen Carbapenem-resistente Enterobakterien wie Escherichia coli oder Klebsiella pneumoniae. Insgesamt untersuchten die Forscherinnen und Forscher mehr als 600 Carbapenem-resistente gramnegative Bakterienisolate. Dabei wiesen sie das IncN-Plasmid deutschlandweit in elf verschiedenen bakteriellen Spezies nach, in Wasserproben aus Fließgewässern sowie bei insgesamt 77 Patienten aus 28 Krankenhäusern in 20 Städten.
„Unsere Studie zeigt, dass die Möglichkeit des Austauschs von Resistenzen über mobile genetische Elemente ein wesentlicher Faktor ist für die erfolgreiche Verbreitung multiresistenter gramnegativer Erreger“, sagt PD Dr. Can Imirzalioglu, Mitautor der Studie und kommissarischer Leiter des Instituts für Medizinische Mikrobiologie der JLU. „Inwiefern hierbei besonders erfolgreiche Plasmide existieren und inwieweit diese im überregionalen Kontext für die Erregerverbreitung maßgeblich sind, war bislang nur unzureichend untersucht.“
Die IncN-Plasmide waren bemerkenswert stabil und wurden bei einzelnen Patienten, die die bakteriellen Erreger trugen, mehr als ein Jahr lang beibehalten. „Die hieraus resultierenden ‚stillen‘ Übertragungsketten sind eine neue Herausforderung für die Überwachung multiresistenter Erreger, die Aufklärung von Ausbrüchen und die Etablierung effektiver Maßnahmen der Hygiene und Infektionsprävention“, so der Erstautor der Studie, Dr. Yancheng Yao vom Institut für Medizinische Mikrobiologie der JLU. „Die Identifizierung solcher Hochrisiko-Plasmide und die Entwicklung neuer Ansätze, um deren Ausbreitung zu reduzieren, sind hochaktuelle Aufgaben der Forschung zum Thema Antibiotikaresistenz.“
„Eine Genom-basierte Überwachung von multiresistenten Erregern erlaubt neben der Aufklärung lokaler Ausbruchsereignisse auch die Detektion von Hochrisiko-Erregern und Resistenzen mit überregionaler und internationaler Bedeutung“, ergänzt Prof. Dr. Trinad Chakraborty, ehemaliger Direktor des Instituts für Medizinische Mikrobiologie der JLU. „Mit konventionellen Methoden lassen sich solche komplexen, auf den ersten Blick nur sehr schwer erkennbaren ‚Plasmidausbrüche’ nicht nachweisen.“
Yancheng Yao et al., Predominant transmission of KPC-2 carbapenemase in Germany by a unique IncN plasmid variant harboring a novel non-transposable element (NTEKPC-Y), in: Antimicrobial Chemotherapy, 12 December 2023, DOI: doi.org/10.1128/spectrum.02564